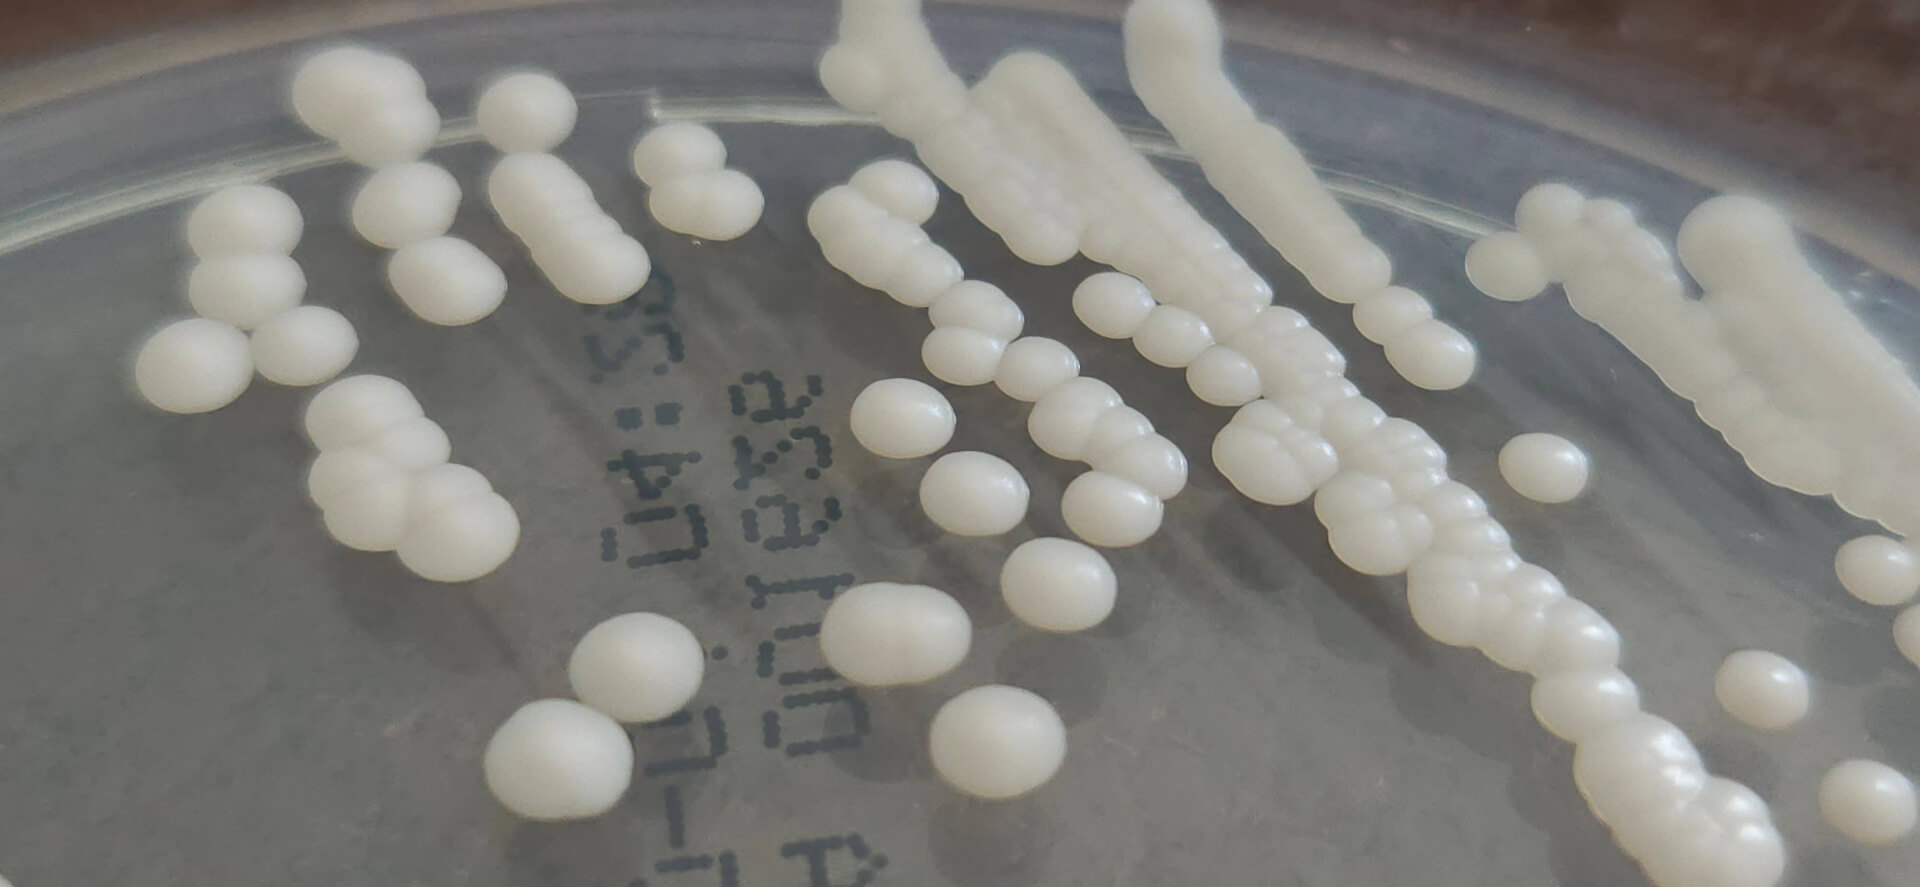
P266 | IICIMED

Characteristics of 123 patients with or without prior atovaquone exposure at the time of P. jirovecii infection diagnoses.
P276
Med. Mycol. 2023, 61, myad095.
Atovaquone exposure and Pneumocystis jirovecii cytochrome b mutations: French data and review of the literature.
https://doi.org/10.1093/mmy/myad095

Structure superposition of HSP90 Homo sapiens (pdb id: 7L7I) with Candida albicans HSP90 model obtained from AlphaFold prediction.
P275
Microorganisms 2023, 11, 2837.
Is the C-terminal domain an effective and selective target for the design of Hsp90 inhibitors against Candida yeast?
https://doi.org/10.3390/microorganisms11122837

ESBL E . coli fecal titers of model 1 (high inoculum, no wash-out): AMX, amoxicillin; PPI, proton pump inhibitor.
P274
J. Appl. Microbiol. 2023, lxad223.
Pantoprazole promotes sustained intestinal carriage of multi-drug resistant Escherichia coli in amoxicillin-treated mice.
https://doi.org/10.1093/jambio/lxad223

Fungal sterol analyses by gas chromatography–mass spectrometry using different derivatives.
P273
In: Barreiro, C., Barredo, JL. (eds) Microbial Steroids. Methods in Molecular Biology, vol 2704. Humana, New York, NY. 2023
Fungal Sterol Analyses by Gas Chromatography–Mass Spectrometry Using Different Derivatives.
https://doi.org/10.1007/978-1-0716-3385-4_8

P272
EMC Maladies Infectieuses, 2023
Les bactéries hautement résistantes aux antibiotiques émergentes et leur prévention.
doi: 10.1016/S1166-8598(23)47346-2

(A) The structure of FCZ and its derivatives 1a-4a was reported in the previous work. (B) The structures of newly developed FCZ derivatives 5a-12a have been developed in this study.
P271
J. Med. Chem. 2023.
Discovery of new broad-spectrum anti-infectives for eukaryotic pathogens using boorganometallic chemistry.
https://doi.org/10.1021/acs.jmedchem.3c01333

P270
J. Fungi 2023, 9, 430.
The mortality attributable to candidemia in C. auris is higher than that in other Candida species: Myth or reality?
https://doi.org/10.3390/jof9040430

Biological activities of Thymelaea tartonraira (L.) All. Extracts.
P269
Nat. Prod. Res. 2023
Phytochemical, antileishmanial, antifungal and cytotoxic profiles of Thymelaea tartonraira (L.) All. extracts.
https://doi.org/10.1080/14786419.2023.2252153

Pharmacomodulation of the 5,6,7,8-tetrahydroimidazo[1,2-a]pyrazine core structure.
P268
Future Microbiol. 2023, 18, 1225-1233.
Antifungal efficacy of imidazo[1,2-a]pyrazine based thiosemicarbazones and thiazolidinediones against Sporothrix species.
https://doi.org/10.2217/fmb-2023-0044

Structure-Activity Relationship: Up arrows represent increasing α-amylase inhibitory.
P267
Chem. Biodivers. 2023, 20, e202200944;
New specific α-glucosidase inhibitor flavonoid from Thymelaea tartonraira leaves: structure elucidation, biological and molecular docking studies.
https://doi.org/10.1002/cbdv.202200944
Yarrowia lipolytica Clinical Isolate CBS 18115
P266
Microbiol. Resour. Announc. 2023, 12, e0126022.
Draft Genome Sequence of the Fluconazole-Resistant Yarrowia lipolytica Clinical Isolate CBS 18115.
https://doi.org/10.1128/mra.01260-22

Flow chart of the Delphi consensus procedure.
P265
JAC Antimicrob. Resist. 2023, 5.
Expert consensus on monitoring antimicrobial stewardship in French nursing homes using assessed reimbursement database indicators.
https://doi.org/10.1093/jacamr/dlad037

Description of collaborations engaged by the CRAtb with the actors involved in the prevention of antibiotic resistance.
P264
Antimicrob. Resist. Infect. Control. 2023, 12:41.
Qualitative assessment of the national initiative to implement antimicrobial stewardship centres in French administrative regions.
https://doi.org/10.1186/s13756-023-01245-9

Cumulative incidence curves for the probability of death in the pre-intervention and the intervention periods.
P263
J. Antimicrob. Chemother. 2023, 78, 1378-1385.
A multifaceted strategy to optimize pharmacokinetics of antimicrobial therapy in patients with hospital-acquired infections-a monocentre quality improvement project.
https://doi.org/10.1093/jac/dkad094

Distributions of initial daily doses administered to patients from the validation dataset with aGFR between 20 and 125 mL/min (pale boxes), and of calculated doses with the nomogram for the same patients (shaded boxes). n=12 for the 20–50 mg/L category and n=20 patients for the >50 mg/L category. Only one patient had a cloxacillin level below 20 mg/L (data not plotted).
P262
J. Antimicrob. Chemother. 2023, 78, 965-974.
Development and validation of a dosing nomogram for continuous infusion cloxacillin in infective endocarditis.
https://doi.org/10.1093/jac/dkad030

Observed versus population-predicted amikacin concentrations (a) and individual-predicted amikacin concentrations (b). Weighted residual error plotted against predicted concentrations (c) and time (d) for population predictions.
P261
Antibiotics 2023, 12,123.
Development of a Predictive Dosing Nomogram to Achieve PK/PD Targets of Amikacin Initial Dose in Critically Ill Patients: A Non-Parametric Approach.
https://doi.org/10.3390/antibiotics12010123

Flow chart for extended-spectrum β-lactamase-producing Enterobacterales (E-ESBL) status at hospital readmission in patients with a history of E-ESBL colonization.
P260
J. Hosp. Infect. 2023, 131, 126-128.
Systematic screening for digestive carriage of extended-spectrum β-lactamase-producing Enterobacterales (E-ESBL) at hospital readmission among patients with past history of E-ESBL colonization or infection.
https://doi.org/10.1016/j.jhin.2022.10.004